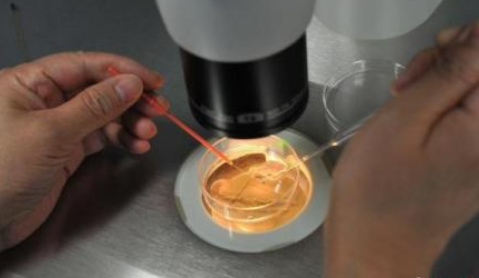
取卵全麻手術(shù)時間多長2018 取卵手術(shù)之后要注意哪些

時間:2018-05-14 18:55:46來源:本站整理作者:zl點擊:
很多人做取卵手術(shù)怕疼會做全身麻醉,按摩取卵全麻手術(shù)時間多長2018 取卵手術(shù)之后要注意哪些,下面八寶網(wǎng)的小編就來為您解答。
一般手術(shù)時間為10-15分鐘,注意術(shù)前8小時禁飲禁食,在您取卵前兩日,有專業(yè)護士會向您詳細(xì)交代具體的注意事項,并發(fā)給您注意事項單。
卵子的質(zhì)量需要取出后,在培養(yǎng)室高倍顯微鏡觀察下才能得以評估。取卵后由于卵子退化或不成熟,可能不受精,造成沒有胚胎可移植。

取卵后會有輕微的下腹不適,一般2-3天緩解或消失;如果取卵數(shù)量較多有可能發(fā)生卵巢過度刺激癥狀:腹脹、惡心、嘔吐、呼吸困難、尿少等,此時您需要盡快復(fù)診,并避免劇烈活動。
適當(dāng)飲水、食用高蛋白食物,并避免劇烈活動,監(jiān)測每日24小時總尿量(小于800ml),必要時及時就醫(yī),以幫助控制腹脹情況。

網(wǎng)友跟帖
Copyright 2015-2020 8bb.com 〖八寶網(wǎng)〗 版權(quán)所有 鄂ICP備19016373號-1
聲明: 本站文章均來自互聯(lián)網(wǎng),不代表本站觀點 如有異議 請與本站聯(lián)系 本站為非贏利性網(wǎng)站 不接受任何贊助和廣告
網(wǎng)友評論僅供其表達個人看法,并不表明八寶網(wǎng)立場。